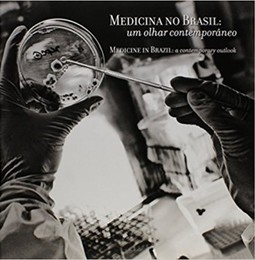

CADASTRE-SE
MEDICINA NO BRASIL / MEDICINE IN BRAZIL: UM OLHAR CONTEMPORÂNEO / A CONTEMPORARY OUTLOOK
Andre Mota , Paulo Fernandes Saad , Karen Ruggeri Saad , Giuseppina Maria Patavino , Izabel Cristina Rios (0) votos | (0) comentários
Sinopse
O homem sempre empreendeu esforços pela busca da saúde, seja por meio da intuição, seja por meio de descobertas, pesquisas ou tecnologia. Neste contexto, esta importante obra traça um panorama sobre questões fundamentais da Medicina no Brasil, trazendo a visão e a experiência de profissionais do setor, sobre o nosso histórico, nossas conquistas, os imensos desafios, etc.
Tratamento de doenças ou tratamento de pessoas? Reação ou prevenção?
Acompanhe todo o impacto destes aspectos em nossa vida.
| Categoria | |
| Editora | Brasileira |
| ISBN-13 | 9788563186096 |
| ISBN | 8563186094 |
| Edição | 1 / 2013 |
| Idioma | Português |
| Páginas | 206 |
| Estante | 0 0 0 0 |
| Sua estante | |
7% chance de ser solicitado
CADASTRE-SE
AVALIAÇÃO DO LEITOR
Quero comentar sobre este livro